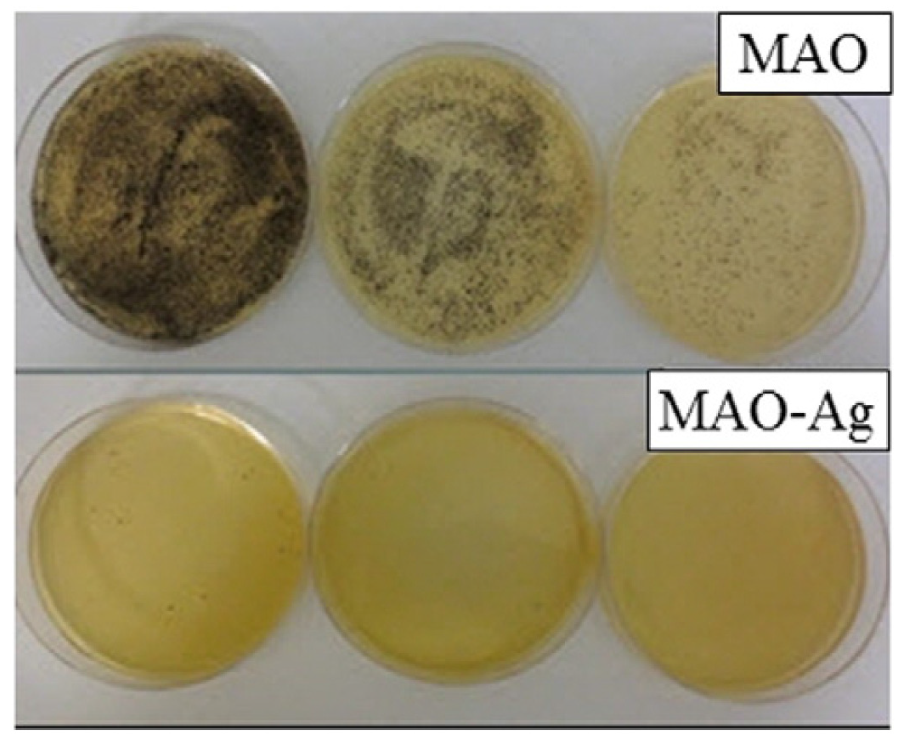
Materials 17 05847 g011

Antibacterial Properties and Biocompatibility of Multicomponent Titanium Oxides: A Review
Abstract
1. Introduction
2. Synthesis Methods
- -
- Solution A was created by dissolving the appropriate amount of barium acetate in butanol to achieve a 0.1 M concentration, with acetic acid acting as a stabilizing agent.
- -
- Solution B consisted of tetra-butyl titanate dissolved in ethylene glycol to form a 0.1 M solution.
3. Morphology
4. In Vitro Tests of Antibacterial Properties and Cytotoxicity
5. In Vitro Tests of Cell Proliferation, Osteoconductivity, and Osteogenic Effect
6. In Vivo Antimicrobial Tests
7. Underlying Mechanisms of Titanates’ Bioactivity
8. Future Applications
9. Conclusions
- The multicomponent compounds of different metallic ions and oxygen are novel antimicrobial and biocompatible materials that are good alternatives to simple oxides like titania, zirconia, and zinc oxide.
- Different synthesis methods like wet chemical conversion, manufacturing of oxide (nano)powders, mechanosynthesis, etc. permit the manufacture of titanates with various morphologies such as, for example, thin films, complicated multilayers, or porous scaffolds.
- Metal ions toxic to bacteria, like silver, barium, calcium, or magnesium, ensure the antimicrobial properties of titanates. However, intrinsic mechanisms like piezocatalysis and photocatalysis can also lead to antimicrobial behavior (investigated mainly with Gram-positive or Gram-negative bacteria, like Escherichia coli or Staphylococcus aureus, or fungi).
- Titanate coatings can improve the cell adhesion, proliferation, and differentiation of the human osteoblast-like cells. In vivo tests have permitted the real applicability of these novel materials to be estimated.
- The possible directions of future developments and novel application areas are described as well as ongoing challenges in scaling up production and the regulatory hurdles to clinical use.
Author Contributions
Funding
Institutional Review Board Statement
Informed Consent Statement
Data Availability Statement
Acknowledgments
Conflicts of Interest
References
- Wadge, M.D.; McGuire, J.; Thomas, K.G.; Stuart, B.W.; Felfel, R.M.; Ahmed, I.; Grant, D.M. Developing alkaline titanate surfaces for medical applications. Int. Mater. Rev. 2023, 68, 677–724. [Google Scholar] [CrossRef]
- Albrektsson, T.; Brånemark, P.-I.; Hansson, H.-A.; Lindström, J. Osseointegrated titanium implants: Requirements for ensuring a long-lasting, direct bone-to-implant anchorage in man. Acta Orthop. Scand. 1981, 52, 155–170. [Google Scholar] [CrossRef] [PubMed]
- Pilliar, R.M. Cementless implant fixation—Toward improved reliability. Orthoped. Clin. N. Am. 2005, 36, 113–119. [Google Scholar] [CrossRef] [PubMed]
- Tsui, Y.; Doyle, C.; Clyne, T. Plasma sprayed hydroxyapatite coatings on titanium substrates part 2: Optimisation of coating properties. Biomaterials 1998, 19, 2031–2043. [Google Scholar] [CrossRef]
- Zhou, H.; Li, F.; He, B.; Wang, J.; Sun, B. Effect of plasma spraying process on microstructure and microhardness of titanium alloy substrate. J. Therm. Spray. Technol. 2008, 17, 284–288. [Google Scholar] [CrossRef]
- Liu, X.; Chu, P.K.; Ding, C. Surface modification of titanium, titanium alloys, and related materials for biomedical applications. Mater. Sci. Eng. R. 2004, 47, 49–121. [Google Scholar] [CrossRef]
- Abu-Amer, Y.; Darwech, I.; Clohisy, J.C. Aseptic loosening of total joint replacements: Mechanisms underlying osteolysis and potential therapies. Arthritis Res. Ther. 2007, 9, S6. [Google Scholar] [CrossRef]
- Tufekci, E.; Brantley, W.A.; Mitchell, J.C.; Foreman, D.W.; Georgette, F.S. Crystallographic characteristics of plasma-sprayed calcium phosphate coatings on Ti-6Al-4V. Inter. J. Oral Maxillofac. Impl. 1999, 14, 661–672. [Google Scholar]
- Purdue, P.E.; Koulouvaris, P.; Nestor, B.J.; Sculco, T.P. The central role of wear debris in periprosthetic osteolysis. HSS J. 2006, 2, 102–113. [Google Scholar] [CrossRef]
- Takadama, H.; Kim, H.M.; Kokubo, T.; Nakamura, T. TEM-EDX study of mechanism of bonelike apatite formation on bioactive titanium metal in simulated body fluid. J. Biomed. Mater. Res. 2001, 57, 441–448. [Google Scholar] [CrossRef]
- Kokubo, T.; Kim, H.-M.; Kawashita, M. Novel bioactive materials with different mechanical properties. Biomaterials 2003, 24, 2161–2175. [Google Scholar] [CrossRef] [PubMed]
- Kokubo, T. Design of bioactive bone substitutes based on biomineralization process. Mater. Sci. Eng. C 2005, 25, 97–104. [Google Scholar] [CrossRef]
- Kokubo, T.; Yamaguchi, S. Bioactive titanate layers formed on titanium and its alloys by simple chemical and heat treatments. Open Biomed. Eng. J. 2015, 9, 29–41. [Google Scholar] [CrossRef] [PubMed]
- Kizuki, T.; Takadama, H.; Matsushita, T.; Nakamura, T.; Kokubo, T. Preparation of bioactive Ti metal surface enriched with calcium ions by chemical treatment. Acta Biomater. 2010, 7, 2836–2842. [Google Scholar] [CrossRef] [PubMed]
- Kizuki, T.; Matsushita, T.; Kokubo, T. Antibacterial and bioactive calcium titanate layers formed on Ti metal and its alloys. J. Mater. Sci. Mater. Med. 2014, 25, 1737–1746. [Google Scholar] [CrossRef]
- Yamaguchi, S.; Matsushita, T.; Kokubo, T. A bioactive Ti metal with a Ca-enriched surface layer releases Mg ions. RSC Adv. 2013, 3, 11274–11282. [Google Scholar] [CrossRef]
- Yamaguchi, S.; Nath, S.; Matsushita, T.; Kokubo, T. Controlled release of strontium ions from a bioactive Ti metal with a Ca-enriched surface layer. Acta Biomater. 2014, 10, 2282–2289. [Google Scholar] [CrossRef]
- Sanaullah, I.; Khan, H.N.; Sajjad, A.; Khan, S.; Sabri, A.N.; Naseem, S.; Riaz, S. Improved osteointegration response using high strength perovskite BaTiO3 coatings prepared by chemical bath deposition. J. Mech. Behav. Biomed. Mater. 2023, 138, 105635. [Google Scholar] [CrossRef]
- Rahmati, S.; Basiriani, M.B.; Rafienia, M.; Yaghini, J.; Raeisi, K. Synthesis and in vitro evaluation of electrodeposited Barium titanate coating on Ti6Al4V. J. Med. Signals Sens. 2016, 6, 106. [Google Scholar] [CrossRef]
- Jianqing, F.; Huipin, Y.; Xingdong, Z. Promotion of osteogenesis by a piezoelectric biological ceramic. Biomaterials 1997, 18, 1531–1534. [Google Scholar] [CrossRef]
- Tang, Y.; Wu, C.; Wu, Z.; Hu, L.; Zhang, W.; Zhao, K. Fabrication and in vitro biological properties of piezoelectric bioceramics for bone regeneration. Sci. Rep. 2017, 7, 43360. [Google Scholar] [CrossRef] [PubMed]
- Pulido-González, N.; Torres, B.; Rodrigo, P.; Hort, N.; Rams, J. Microstructural, mechanical and corrosion characterization of an as-cast Mg–3Zn–0.4Ca alloy for biomedical applications. J. Magnes. Alloys 2020, 8, 510–522. [Google Scholar] [CrossRef]
- Kayhan, S.M.; Tahmasebifar, A.; Koç, M.; Usta, Y.; Tezcaner, A.; Evis, Z. Experimental and numerical investigations for mechanical and microstructural characterization of micro-manufactured AZ91D magnesium alloy disks for biomedical applications. Mater. Des. 2016, 93, 397–408. [Google Scholar] [CrossRef]
- Saranya, K.; Bhuvaneswari, S.; Suvro, C.; Rajendran, N. Titanate incorporated anodized coating on magnesium alloy for corrosion protection, antibacterial responses and osteogenic enhancement. J. Magnes. Alloys 2022, 10, 1109–1123. [Google Scholar] [CrossRef]
- Wadge, M.D.; Turgut, B.; Murray, J.W.; Stuart, B.W.; Felfel, R.M.; Ahmed, I.; Grant, D.M. Developing highly nanoporous titanate structures via wet chemical conversion of DC magnetron sputtered titanium thin films. J. Coll. Interf. Sci. 2020, 566, 271–283. [Google Scholar] [CrossRef]
- Kokubo, T.; Yamaguchi, S. Novel bioactive titanate layers formed on Ti metal and its alloys by chemical treatments. Materials 2010, 3, 48–63. [Google Scholar] [CrossRef]
- Kim, H.-M.; Miyaji, F.; Kokubo, T.; Nishiguchi, S.; Nakamura, T. Graded surface structure of bioactive titanium prepared by chemical treatment. J. Biomed. Mater. Res. 1999, 45, 100–107. [Google Scholar] [CrossRef]
- Yamaguchi, S.; Takadama, H.; Matsushita, T.; Nakamura, T.; Kokubo, T. Cross-sectional analysis of the surface ceramic layer developed on Ti metal by NaOH-heat treatment and soaking in SBF. J. Ceram. Soc. Jpn. 2009, 117, 1126–1130. [Google Scholar] [CrossRef]
- Kawai, T.; Kizuki, T.; Takadama, H.; Matsushita, T.; Unuma, H.; Nakamura, T.; Kokubo, T. Apatite formation on surface titanate layer with different Na content on Ti metal. J. Ceram. Soc. Jpn. 2010, 118, 19–24. [Google Scholar] [CrossRef]
- Rodríguez-Contreras, A.; Torres, D.; Piñera-Avellaneda, D.; Pérez-Palou, L.; Ortiz-Hernández, M.; Ginebra, M.P.; Calero, J.A.; Manero, J.M.; Rupérez, E. Dual-action effect of gallium and silver providing osseointegration and antibacterial properties to calcium titanate coatings on porous titanium implants. Int. J. Mol. Sci. 2023, 24, 8762. [Google Scholar] [CrossRef]
- Wang, Y.; Teng, W.; Zhang, Z.; Zhou, X.; Ye, Y.; Lin, P.; Liu, A.; Wu, Y.; Li, B.; Zhang, C.; et al. A trilogy antimicrobial strategy for multiple infections of orthopedic implants throughout their life cycle. Bioact. Mater. 2021, 6, 1853–1866. [Google Scholar] [CrossRef] [PubMed]
- Sana Ullah, I.; Khan, S.; Ali, D.; Sajjad, A.; Shamaila, S.; Kanwal, Z.; Sabri, A.N.; Atiq, S.; Naseem, S.; Saira Riaz, S. Investigation and optimization of In-Vitro behaviour of Perovskite barium titanate as a scaffold and protective coatings. J. Mech. Behav. Biomed. Mater. 2024, 149, 106215. [Google Scholar] [CrossRef]
- Tian, Y.; Fujibayashi, S.; Yamaguchi, S.; Matsushita, T.; Kokubo, T.; Matsuda, S. In vivo study of the early bone-bonding ability of Ti meshes formed with calcium titanate via chemical treatments. J. Mater. Sci. Mater. Med. 2015, 26, 271. [Google Scholar] [CrossRef] [PubMed]
- Kokubo, T.; Yamaguchi, S. Bioactive Ti metal and its alloys prepared by chemical treatments: State-of-the-art and future trends. Adv. Eng. Mater. 2010, 12, B579–B591. [Google Scholar] [CrossRef]
- Kokubo, T.; Yamaguchi, S. Biomineralization of metals using chemical and heat treatments. Biominer. Biomater. 2016, 11, 339–364. [Google Scholar] [CrossRef]
- Wang, Y.; Gou, Z.; Ma, S.; Jin, Z.; Chen, S.; Ye, J.; Nie, Z.; Wan, Z.; Zhang, C.; Ye, Y.; et al. Remote eradication of delayed infection on orthopedic implants via magnesium-based total morphosynthesis of biomimetic mineralization strategy. Mater. Des. 2023, 233, 112233. [Google Scholar] [CrossRef]
- Wei, Y.; Hu, X.; Shao, J.; Wang, S.; Zhang, Y.; Xie, W.-Z.; Wu, Y.-X.; Zeng, X.-T.; Zhang, L.-L. Daily sonic toothbrush triggered biocompatible BaTiO3/chitosanmultiporous coating with enhanced piezocatalysis for intraoral antibacterial activity. Mater. Today Comm. 2024, 38, 107715. [Google Scholar] [CrossRef]
- Prokhorov, E.; Barcenas, G.L.; Sanchez, B.L.E.; Franco, B.; Padilla-Vaca, F.; Landaverde, M.A.H.; Limon, J.M.Y.; Lopez, R.A. Chitosan-BaTiO3 nanostructured piezopolymer for tissue engineering. Colloid Surf. B 2020, 196, 111296. [Google Scholar] [CrossRef]
- Liang, S.; Jian, L.; Wang, D.; Peng, F. Enhancement of antibacterial and cytocompatibility of Ti by Zn-doped BST coatings. Mater. Lett. 2023, 338, 134018. [Google Scholar] [CrossRef]
- Teker, D.; Muhaffel, F.; Menekse, M.; Karaguler, N.G.; Baydogan, M.; Cimenoglu, H. Characteristics of multi-layer coating formed on commercially pure titanium for biomedical applications. Mater. Sci. Eng. C 2015, 48, 579–585. [Google Scholar] [CrossRef]
- Takemoto, M.; Fujibayashi, S.; Neo, M.; Suzuki, J.; Kokubo, T.; Nakamura, T. Mechanical properties and osteoconductivity of porous bioactive titanium. Biomaterials 2005, 26, 6014–6023. [Google Scholar] [CrossRef] [PubMed]
- Simka, W.; Sowa, M.; Socha, R.P.; Maciej, A.; Michalska, J. Anodic oxidation of zirconium in silicate solutions. Electrochim. Acta 2013, 104, 518–525. [Google Scholar] [CrossRef]
- Li, L.H.; Kim, H.W.; Lee, S.H.; Kong, Y.M.; Kim, H.E. Biocompatibility of titanium implants modified by microarc oxidation and hydroxyapatite coating. J. Biomed. Mater. Res. A 2005, 73, 48–54. [Google Scholar] [CrossRef] [PubMed]
- Yada, V.; Inoue, Y.; Noda, I.; Morita, T.; Torikai, T.; Watari, T.; Hotokebuchi, T. Antibacterial Properties on titanate nanofiber thin films formed on a titanium plate. J. Nanomater. 2013, 2013, 476585. [Google Scholar] [CrossRef]
- Thukkaram, M.; Coryn, R.; Asadian, M.; Tabaei, P.S.E.; Rigole, P.; Rajendhran, N.; Nikiforov, A.; Sukumaran, S.; Coenye, T.; van der Voort, P.; et al. Fabrication of microporous coatings on titanium implants with improved mechanical, antibacterial, and cell-interactive properties. ACS Appl. Mater. Interfaces 2020, 12, 30155–30169. [Google Scholar] [CrossRef]
- Sandomierski, M.; Jakubowski, M.; Ratajczak, M.; Voelkel, A. Drug distribution evaluation using FT-IR imaging on the surface of a titanium alloy coated with zinc titanate with potential application in the release of drugs for osteoporosis. Spectr. Acta A 2022, 281, 121575. [Google Scholar] [CrossRef]
- Sreya, P.V.; Mathew, A.M.; Gowdhami, B.; Vignesh, K.; Swathi, C.M.; Venkatesan, K.; Kadalmani, B.; Pattanayak, D.K. Biomimetic surface functionalization of Ti metal incorporated with Ca-Zn and evaluation of in-vitro biological properties. Surf. Interf. 2023, 42, 103425. [Google Scholar] [CrossRef]
- Yao, L.; Wang, H.; Li, L.; Cao, Z.; Dong, Y.; Yao, L.; Lou, W.; Zheng, S.; Shi, Y.; Shen, X.; et al. Development and evaluation of osteogenesis and antibacterial properties of strontium/silver-functionalized hierarchical micro/nano-titanium implants. Mater. Des. 2022, 224, 111425. [Google Scholar] [CrossRef]
- Yamaguchi, S.; Nath, S.; Sugawara, Y.; Divakarla, K.; Das, T.; Manos, J.; Chrzanowski, W.; Matsushita, T.; Kokubo, T. Two-in-one biointerfaces—Antimicrobial and bioactive nanoporous gallium titanate layers for titanium implants. Nanomaterials 2017, 7, 229. [Google Scholar] [CrossRef]
- Arsecularatne, J.A.; Colusso, E.; Della Gaspera, E.; Martucci, A.; Hoffman, M.J. Nanomechanical and tribological characterization of silk and silk-titanate composite coatings. Trib. Int. 2020, 146, 106195. [Google Scholar] [CrossRef]
- Perotto, G.; Cittadini, M.; Tao, H.; Kim, S.; Yang, M.; Kaplan, D.L.; Martucci, A.; Omenetto, F.G. Fabrication of tunable high refractive index titanate-silk nanocomposites on the micro- and nanoscale. Adv. Mater. 2015, 27, 6728–6732. [Google Scholar] [CrossRef] [PubMed]
- Wang, B.; Wu, Z.; Lan, J.; Li, Y.; Xie, L.; Huang, X.; Zhang, A.; Qiao, H.; Chang, X.; Lin, H.; et al. Surface modification of titanium implants by silk fibroin/Ag co-functionalized strontium titanate nanotubes for inhibition of bacterial-associated infection and enhancement of in vivo osseointegration. Surf. Coat. Technol. 2021, 405, 126700. [Google Scholar] [CrossRef]
- Zhang, G.; Wang, D.; Yan, J.; Xiao, Y.; Gu, W.; Zang, C. Study on the photocatalytic and antibacterial properties of TiO2 Nanoparticles-coated cotton fabrics. Materials 2019, 12, 2010. [Google Scholar] [CrossRef] [PubMed]
- Kumar, A.; Sharma, M.; Vaish, R. BaTiO3 Nanoparticles embedded antibacterial cotton fabric with UV protection characteristics. J. Nat. Fibers 2023, 20, 2139325. [Google Scholar] [CrossRef]
- Kumar, A.; Sharma, M.; Amari, A.; Vaish, R. Sonocatalytic induced dye degradation and antibacterial performance of SrTiO3 nanoparticles embedded cotton fabric. Environ. Res. 2024, 240, 117541. [Google Scholar] [CrossRef]
- Tóthová, E.; Witte, R.; Hegedüs, M.; Senna, M.; Hahn, H.; Heitjans, P.; Šepelák, V. Mechanochemical syntheses of LiFeGe2O6-based nanocomposite and novel nanoglassy LiFeTi2O6. J. Mater. Sci. 2018, 53, 13530–13537. [Google Scholar] [CrossRef]
- Shams, M.H.; Rozatian, A.S.H.; Yousefi, M.H.; Valíček, J.; Šepelák, V. Effect of Mg2+ and Ti4+ dopants on the structural, magnetic and high-frequency ferromagnetic properties of bariumhexaferrite. J. Magn. Magn. Mater. 2016, 399, 10–18. [Google Scholar] [CrossRef]
- Senna, M.; Fabián, M.; Kavan, L.; Zukalová, M.; Briančin, J.; Turianicová, E.; Bottke, P.; Wilkening, M.; Šepelák, V. Electrochemical properties of spinel Li4Ti5O12 nanoparticles prepared via a low-temperature solid route. J. Sol. State Electrochem. 2016, 20, 2673–2683. [Google Scholar] [CrossRef]
- Edalati, K. Review on recent advancements in severe plastic deformation of oxides by high-pressure torsion (HPT). Adv. Eng. Mater. 2019, 21, 1800272. [Google Scholar] [CrossRef]
- Razavi-Khosroshahi, H.; Edalati, K.; Hirayama, M.; Emami, H.; Arita, M.; Yamauchi, M.; Hagiwara, H.; Ida, S.; Ishihara, T.; Akiba, E.; et al. Visible-light-driven photocatalytic hydrogen generation on nanosized TiO2-II stabilized by high-pressure torsion. ACS Catal. 2016, 6, 5103–5107. [Google Scholar] [CrossRef]
- Razavi-Khosroshahi, H.; Edalati, K.; Wu, J.; Nakashima, Y.; Arita, M.; Ikoma, Y.; Sadakiyo, M.; Inagaki, Y.; Staykov, A.; Yamauchi, M.; et al. High-pressure zinc oxide phase as visible-light-active photocatalyst with narrow band gap. J. Mater. Chem. A 2017, 5, 20298–20303. [Google Scholar] [CrossRef]
- Fujita, I.; Edalati, K.; Sauvage, X.; Horita, Z. Grain growth in nanograined aluminum oxide by high-pressure torsion: Phase transformation and plastic strain effects. Scr. Mater. 2018, 152, 11. [Google Scholar] [CrossRef]
- Edalati, K.; Arimura, M.; Ikoma, Y.; Daio, T.; Miyata, M.; Smith, D.J.; Horita, Z. Plastic deformation of BaTiO3 ceramics by high-pressure torsion and changes in phase transformations, optical and dielectric properties. Mater. Res. Lett. 2015, 3, 216. [Google Scholar] [CrossRef]
- Edalati, P.; Wang, Q.; Razavi-Khosroshahi, H.; Fuji, M.; Ishihara, T.; Edalati, K. Photocatalytic hydrogen evolution on a highentropy oxide. J. Mater. Chem. A 2020, 8, 3814. [Google Scholar] [CrossRef]
- Straumal, B.B.; Mazilkin, A.A.; Protasova, S.G.; Myatiev, A.A.; Straumal, P.B.; Schütz, G.; van Aken, P.A.; Goering, E.; Baretzky, B. Grain-boundary induced high Tc-ferromagnetism in pure and doped nanocrystalline ZnO. Phys. Rev. B 2009, 79, 205206. [Google Scholar] [CrossRef]
- Straumal, B.B.; Mazilkin, A.A.; Protasova, S.G.; Myatiev, A.A.; Straumal, P.B.; Goering, E.; Baretzky, B. Influence of texture on the ferromagnetic properties of nanograined ZnO films. Phys. Stat. Sol. B 2011, 248, 581–586. [Google Scholar] [CrossRef]
- Straumal, B.B.; Mazilkin, A.A.; Protasova, S.G.; Straumal, P.B.; Myatiev, A.A.; Goering, E.; Baretzky, B. Ferromagnetism of nanostructured zinc oxide films. Phys. Metal. Metallogr. 2012, 113, 1244–1256. [Google Scholar] [CrossRef]
- Straumal, B.B.; Protasova, S.G.; Mazilkin, A.A.; Straumal, P.B.; Schütz, G.; Tietze, T.; Goering, E.; Baretzky, B. Ferromagnetic behaviour of Fe-doped nanograined ZnO films. Beilstein J. Nanotechnol. 2013, 4, 361–369. [Google Scholar] [CrossRef]
- Protasova, S.G.; Straumal, B.B.; Mazilkin, A.A.; Stakhanova, S.V.; Straumal, P.B.; Baretzky, B. Increase of Fe solubility in ZnO induced by the grain boundary adsorption. J. Mater. Sci. 2014, 49, 4490–4498. [Google Scholar] [CrossRef]
- Edalati, K.; Ahmed, A.Q.; Akrami, S.; Ameyama, K.; Aptukov, V.; Asfandiyarov, R.N.; Ashida, M.; Astanin, V.; Bachmaier, A.; Beloshenko, V.; et al. Severe plastic deformation for producing superfunctional ultrafine-grained and heterostructured materials: An interdisciplinary review. J. Alloys Compd. 2024, 1002, 174667. [Google Scholar] [CrossRef]
- Rodríguez-Contreras, A.; Torres, D.; Rafik, B.; Ortiz-Hernandez, M.; Ginebra, M.P.; Calero, J.A.; Manero, J.M.; Ruperez, E. Bioactivity and antibacterial properties of calcium- and silver-doped coatings on 3D printed titanium scaffolds. Surf. Coat. Technol. 2021, 421, 127476. [Google Scholar] [CrossRef]
- Su, Y.H.; Yin, Z.F.; Xin, H.L.; Zhang, H.Q.; Sheng, J.Y.; Yang, Y.L.; Du, J.; Ling, C.Q. Optimized antimicrobial and antiproliferative activities of titanate nanofibers containing silver. Int. J. Nanomed. 2011, 6, 1579–1586. [Google Scholar] [CrossRef] [PubMed]
- Ameur, N.; Bachir, R. Study of 1D titanate-based materials—New modification of the synthesis procedure and surface properties-recent applications. Chem. Select 2020, 5, 1164–1185. [Google Scholar] [CrossRef]
- Ameur, N.; Ferouani, G.; Belkadi, Z.; Bachir, R.; Calvino, J.J.; Hakkoum, A. A novel approach for the preparation of silver nanoparticles supported on titanate nanotubes and bentonite-application in the synthesis of heterocyclic compound derivatives. Mater. Res. Express 2019, 6, 125051. [Google Scholar] [CrossRef]
- Bouayed, M.; Ameur, N.; Taieb-Brahimi, F.; Hidouri, T.; Naser, S.; Ghouas, H.; Bedrane, S.; Al-Shahri, B.M.; Bachir, R. Investigation of novel titanate nanotubes modified with Ce, Fe, Zn and Zr for efficient dye degradation performance, inhibition of bacterial and fungal growth and anticorrosion activity in acid medium. React. Kinet. Mech. Catal. 2021, 134, 517–537. [Google Scholar] [CrossRef]
- Yu, X.; Wang, S.; Zhang, X.; Qi, A.; Qiao, X.; Liu, Z.; Wu, M.; Li, L.; Wang, Z.L. Heterostructured nanorod array with piezophototronic and plasmonic effect for photodynamic bacteria killing and wound healing. Nano Energy 2018, 46, 29–38. [Google Scholar] [CrossRef]
- Rodríguez-Contreras, A.; Torresa, D.; Guillem-Marti, J.; Sereno, P.; Pau Ginebr, M.; Calero, J.A.; Manero, J.M.; Rupérez, E. Development of novel dual-action coatings with osteoinductive and antibacterial properties for 3D-printed titanium implants. Surf. Coat. Technol. 2020, 403, 126381. [Google Scholar] [CrossRef]
- Ehlert, M.; Radtke, A.; Forbot, N.; Jędrzejewski, T.; Roszek, K.; Golińska, P.; Trykowski, G.; Piszczek, P. TiO2/HA and titanate/HA double-layer coatings on Ti6Al4V surface and their influence on in vitro cell growth and osteogenic potential. J. Funct. Biomater. 2022, 13, 271. [Google Scholar] [CrossRef]
- Ehlert, M.; Radtke, A.; Roszek, K.; Jedrzejewski, T.; Piszczek, P. Assessment of titanate nanolayers in terms of their physicochemical and biological properties. Materials 2021, 14, 806. [Google Scholar] [CrossRef]
- Jin, S.; Cao, J.; Li, J.; Han, J.; Mei, C.; Li, K.; Xiao, H. Biomass-based functional film integrated with nitrogen-coordinating boronic ester and cellulose-barium titanate nanohybrids. Ind. Crops Prod. 2022, 189, 115765. [Google Scholar] [CrossRef]
- Raphel, J.; Holodniy, M.; Goodman, S.B.; Heilshorn, S.C. Multifunctional coatings to simultaneously promote osseointegration and prevent infection of orthopaedic implants. Biomaterials 2016, 84, 301–314. [Google Scholar] [CrossRef] [PubMed]
- Vimbela, G.V.; Ngo, S.M.; Fraze, C.; Yang, L.; Stout, D.A. Antibacterial properties and toxicity from metallic nanomaterials. Int. J. Nanomed. 2017, 12, 3941–3965. [Google Scholar] [CrossRef] [PubMed]
- Cheng, Y.; Feng, G.; Moraru, C.I. Micro- and nanotopography sensitive bacterial attachment mechanisms: A review. Front. Microbiol. 2019, 10, 191. [Google Scholar] [CrossRef] [PubMed]
- Almaguer-Flores, A.; Silva-Bermudez, P.; Galicia, R.; Rodil, S.E. Bacterial adhesion on amorphous and crystalline metal oxide coatings. Mater. Sci. Eng. C 2015, 57, 88–99. [Google Scholar] [CrossRef] [PubMed]
- Rodriguez-Contreras, A.; Guadarrama Bello, D.; Flynn, S.; Variola, F.; Wuest, J.D.; Nanci, A. Chemical nanocavitation of surfaces to enhance the utility of stainless steel as a medical material. Coll. Surf. B Biointerf. 2018, 161, 677–687. [Google Scholar] [CrossRef]
- Rodriguez-Contreras, A.; Guadarrama Bello, D.; Nanci, A. Surface nanoporosity has a greater influence on osteogenic and bacterial cell adhesion than crystallinity and wettability. Appl. Surf. Sci. 2018, 445, 256–261. [Google Scholar] [CrossRef]
- Mitik-Dineva, N.; Wang, J.; Mocanasu, R.C.; Stoddart, P.R.; Crawford, R.J.; Ivanova, E.P. Impact of nano-topography on bacterial attachment. Biotechnol. J. 2008, 3, 536–544. [Google Scholar] [CrossRef]
- Variola, F.; Zalzal, S.F.; Leduc, A.; Barbeau, J.; Nanci, A. Oxidative nanopatterning of titanium generates mesoporous surfaces with antimicrobial properties. Int. J. Nanomed. 2014, 9, 2319–2325. [Google Scholar] [CrossRef]
- Durmus, N.G.; Webster, T.J. Nanostructured titanium: The ideal material for improving orthopedic implant efficacy? Nanomedicine 2012, 7, 791–793. [Google Scholar] [CrossRef]
- Straumal, B.B.; Gornakova, A.S.; Kiselevskiy, M.V.; Anisimova, N.Y.; Nekrasov, A.N.; Kilmametov, A.R.; Strug, R.; Rabkin, E. Optimal surface roughness of Ti6Al4V alloy for the adhesion of cells with osteogenic potential. J. Mater. Res. 2022, 37, 2661–2674. [Google Scholar] [CrossRef]
- Xue, Y.; Zhang, L.; Liu, F.; Dai, F.; Kong, L.; Ma, D.; Han, Y. Alkaline “nanoswords” coordinate ferroptosis-like bacterial death for antibiosis and osseointegration. ACS Nano 2023, 17, 2711–2724. [Google Scholar] [CrossRef] [PubMed]
- Sikder, P.; Coomar, P.P.; Mewborn, J.M.; Bhaduri, S.B. Antibacterial calcium phosphate composite cements reinforced with silver-doped magnesium phosphate (newberyite) micro-platelets. J. Mech. Behav. Biomed. Mater. 2020, 110, 103934. [Google Scholar] [CrossRef] [PubMed]
- Khare, D.; Basu, B.; Dubey, A.K. Electrical stimulation and piezoelectric biomaterials for bone tissue engineering applications. Biomaterials 2020, 258, 120280. [Google Scholar] [CrossRef]
- Liu, S.; Wang, W.; Xu, W.; Liu, L.; Zhang, W.; Song, K.; Chen, X. Continuous three dimensional printing of architected piezoelectric sensors in minutes. Research 2022, 2022, 9790307. [Google Scholar] [CrossRef]
- Su, C.; Zhang, L.; Zhang, Y.; Huang, X.; Ye, Y.; Xia, Y.; Gong, Z.; Qin, X.; Liu, Y.; Guo, S. P(VDF-TrFE)/BaTiO3 nanofibrous membrane with enhanced piezoelectricity for high PM0.3 filtration and reusable face masks. ACS Appl. Mater. 2023, 15, 5845–5855. [Google Scholar] [CrossRef]
- Jiang, B.; Iocozzia, J.; Zhao, L.; Zhang, H.; Harn, Y.-W.; Chen, Y.; Lin, Z. Barium titanate at the nanoscale: Controlled synthesis and dielectric and ferroelectric properties. Chem. Soc. Rev. 2019, 48, 1194–1228. [Google Scholar] [CrossRef]
- Bell, J.G.; Graule, T.; Stuer, M. Barium titanate-based thermistors: Past achievements, state of the art, and future perspectives. Appl. Phys. Rev. 2021, 8, 031318. [Google Scholar] [CrossRef]
- Xia, G.; Song, B.; Fang, J. Electrical stimulation enabled via electrospun piezoelectric polymeric nanofibers for tissue regeneration. Research 2022, 2022, 9896274. [Google Scholar] [CrossRef]
- Liu, Z.; Yu, X.; Li, L. Piezopotential augmented photo- and photoelectro-catalysis with a built-in electric field. Chin. J. Catal. 2020, 41, 534–549. [Google Scholar] [CrossRef]
- Shah, A.A.; Khan, A.; Dwivedi, S.; Musarrat, J.; Azam, A. Antibacterial and antibiofilm activity of barium titanate nanoparticles. Mater. Lett. 2018, 229, 130–133. [Google Scholar] [CrossRef]
- Wang, R.; Zhou, T.; Liu, J.; Zhang, X.; Yang, J.; Hu, W.; Liu, L. Designing novel antibiofouling coatings on titanium based on the ferroelectric-induced strategy. Mater. Des. 2021, 203, 109584. [Google Scholar] [CrossRef]
- Kumar, S.; Sharma, M.; Powar, S.; Kabachkov, E.N.; Vaish, R. Impact of remnant surface polarization on photocatalytic and antibacterial performance of BaTiO3. J. Eur. Ceram. Soc. 2019, 39, 2915–2922. [Google Scholar] [CrossRef]
- Wang, Y.; Wen, X.; Jia, Y.; Huang, M.; Wang, F.; Zhang, X.; Bai, Y.; Yuan, G.; Wang, Y. Piezo-catalysis for nondestructive tooth whitening. Nat. Commun. 2020, 11, 1328. [Google Scholar] [CrossRef] [PubMed]
- Lei, J.; Wang, C.; Feng, X.; Ma, L.; Liu, X.; Luo, Y.; Tan, L.; Wu, S.; Yang, C. Sulfur-regulated defect engineering for enhanced ultrasonic piezocatalytic therapy of bacteria-infected bone defects. Chem. Eng. J. 2022, 435, 134624. [Google Scholar] [CrossRef]
- Wu, M.; Zhang, Z.; Liu, Z.; Zhang, J.; Zhang, Y.; Ding, Y.; Huang, T.; Xiang, D.; Wang, Z.; Dai, Y.; et al. Piezoelectric nanocomposites for sonodynamic bacterial elimination and wound healing. Nano Today 2021, 37, 101104. [Google Scholar] [CrossRef]
- Carvalho, E.O.; Fernandes, M.M.; Padrao, J.; Nicolau, A.; Marques-Marchan, J.; Asenjo, A.; Gama, F.M.; Ribeiro, C.; Lanceros-Mendez, S. Tailoring bacteria response by piezoelectric stimulation. ACS Appl. Mater. 2019, 11, 27297–27305. [Google Scholar] [CrossRef]
- Yan, W.Q.; Nakamura, T.; Kobayashi, M.; Kim, H.M.; Miyaji, F.; Kokubo, T. Bonding of chemically treated titanium implants to bone. J. Biomed. Mater. Res. A 1997, 37, 267–275. [Google Scholar] [CrossRef]
- Nishiguchi, S.; Kato, H.; Fujita, H.; Oka, M.; Kim, H.M.; Kokubo, T.; Nakamura, T. Titanium metals form direct bonding to bone after alkali and heat treatments. Biomaterials 2001, 22, 2525–2533. [Google Scholar] [CrossRef]
- Nishiguchi, S.; Kato, H.; Fujita, H.; Kim, H.M.; Miyaji, F.; Kokubo, T.; Nakamura, T. Enhancement of bone-bonding strengths of titanium alloy implants by alkali and heat treatments. J. Biomed. Mater. Res. A 1999, 48, 689–696. [Google Scholar] [CrossRef]
- Zhu, Y.; Wang, X.; Zhou, Y.; Zhao, C.; Yuan, J.; Wu, Z.; Wu, S.; Wang, S. In situ formation of bioactive calcium titanate coatings on titanium screws for medical implants. RSC Adv. 2016, 6, 53182–53187. [Google Scholar] [CrossRef]
- Gathen, M.; Ploeger, M.M.; Jaenisch, M.; Koob, S.; Cucchi, D.; Kasapovic, A.; Randau, T.; Placzek, R. Outcome evaluation of new calcium titanate Schanz-Screws for external fixators. First clinical results and cadaver studies. J. Mater. Sci. Mater. Med. 2019, 30, 124. [Google Scholar] [CrossRef] [PubMed]
- Uchida, M.; Kim, H.M.; Kokubo, T.; Fujibayashi, S.; Nakamura, T. Effect of water treatment on the apatite-forming ability of NaOH-treated titanium metal. J. Biomed. Mater. Res. A 2002, 63, 522–530. [Google Scholar] [CrossRef] [PubMed]
- Fujibayashi, S.; Takemoto, M.; Neo, M.; Matsushita, T.; Kokubo, T.; Doi, K.; Ito, T.; Shimizu, A.; Nakamura, T. A novel synthetic material for spinal fusion: A prospective clinical trial of porous bioactive titanium metal for lumbar interbody fusion. Eur. Spine J. 2011, 20, 1486–1495. [Google Scholar] [CrossRef] [PubMed]
- Camargo, W.A.; Takemoto, S.; Hoekstra, J.W.; Sander, C.; Leeuwenburgh, G.; Jansen, J.A.; Jeroen, J.; van den Beucken, J.P.; Alghamdi, H.S. Effect of surface alkali-based treatment of titanium implants on ability to promote in vitro mineralization and in vivo bone formation. Acta Biomater. 2017, 57, 511–523. [Google Scholar] [CrossRef]
- Mohanta, M.; Thirugnanam, A. Development of multifunctional commercial pure titanium-polyethylene glycol drug-eluting substrates with enhanced optical and antithrombotic properties. Cardiovasc. Eng. Technol. 2023, 14, 27–51. [Google Scholar] [CrossRef]
- Yamaguchi, S.; Akeda, K.; Shintani, S.A.; Sudo, A.; Matsushita, T. Drug-releasing gelatin coating reinforced with calcium titanate formed on Ti–6Al–4V alloy designed for osteoporosis bone repair. Coatings 2022, 12, 139. [Google Scholar] [CrossRef]
- Ndebele, P.; Blanchard-Horan, C.; Shahkolahi, A.; Sanne, I. Regulatory challenges associated with conducting multi-country clinical trials in resource-limited settings. J. Acquir. Immune Defic. Syndr. 2014, 65, S29–S31. [Google Scholar] [CrossRef]

| Method | Details of Technology | Materials | Advantages and Drawbacks | References |
|---|---|---|---|---|
| Chemical modification of titanium substrates | Ti immersed in a 5 M NaOH aqueous solution with subsequent heat treatments at 600 °C. | Titanium substrate, formation of Na titanate layer. | Nanoporous structures good for orthopedic applications. Increased surface roughness of titanate converted samples (ca. 52–140 nm) and good adherence strength. | [25,27,28,29] |
| Thermomechanical process | Porous Ti cylinders produced via 3D printing using direct ink-writing technology. | Ca titanate obtained by immersion in a Ca acetate solution (100 mM) mixed with 10 mL Ga and Ag nitrate solutions. | The dual effect of Ga and Ag metallic agents doping the titanium surface provides bioactivity while protecting the biomaterial from the most frequent pathogens in implantology. | [14,30] |
| Spin coating | Mineralization combined with ion exchange. | Magnesium-substituted sodium titanate. | Titanate-incorporated anodized coatings provide corrosion protection, antibacterial properties, and osteogenic enhancement. | [36,37,38,39] |
| Chemical bath deposition method | Barium acetate Ba(CH3COO)2 and tetra-butyl titanate Ti(C4H9O)4 serve as precursors. | Barium titanate coatings. | Coatings are produced without the use of hazardous solvents/reagents. Good biodegradation properties, small values of weight loss after immersion in simulated body fluid. High antioxidant activity. | [18] |
| Micro-arc oxidation (MAO) | MAO is an electrochemical process akin to conventional anodizing with higher potentials. | MAO included in non-toxic, environmentally friendly electrolytes. | Promising technique for surface modification. Enhances the bioactivity of titanium-based implants. | [40,41,42,43] |
| Plasma electrolytic oxidation (PEO) | PEO converts the surface of Ti to anatase and rutile, hydroxyapatite, and calcium titanate. | Thin titanates films enriched with Ca, P, and Ag atoms are produced. | The developed coatings exhibit a more porous morphology with an improved surface wettability, roughness, microhardness, and frictional coefficient. | [45] |
| Immersion | Immersion of a nanostructured sodium hydrogen titanate layer in a mixed solution of CaCl2 and GaCl3. | Replacement of Na ions with Ca and Ga ions with final heat treatment at 600 °C. | Unique combination of antimicrobial and bioactive properties. Such dual activity is essential for the next generation of orthopedic and dental implants. | [49] |
| Silk-based nanocomposite coatings | A solution of silk fibroin (SF) and a water dispersion of titanate nanocomposites (TNSs) were prepared. | The crosslinking effect of silk fibroin slows down the release of Ag+ ions, avoiding the sudden release of ions, extending its antibacterial cycle. | Good tribological and mechanical properties of silk-based nanocomposite coatings. Applications in optics, biomedicine, and dentistry, owing to the exceptional mechanical/optical properties and associated biocompatibility of silk. | [50,51,52] |
| Mechanosynthesis in planetary mill | A stoichiometric mixture of powdered precursors, consisting of Fe2O3, Li2O, and GeO2 or TiO2 is milled. | The germanate-type LiFeGe2O6 and the titanate-type LiFeTi2O6 pyroxenes are prepared via one-step mechanosynthesis in a planetary mill. | Small grain size, just one step in synthesis process, can be amorphous. | [56,57,58] |
| Mechanosynthesis by high-pressure torsion (HPT). | Precursors of titanates are mixed, pressed together, and deformed by torsion at a pressure of 5–12 GPa. | Titanates like BaTiO3 or a mixture of monoclinic and orthorhombic perovskites TiHfZrNbTaO11. | Homogenous and nanocrystalline structure. Doped grain boundaries. | [59,60,61,62,63,64] |
| 3D printing | With an ink composed of 99.5% pure titanium powder and hydrogel. | Immersion of porous Ti cylinders in solutions of Ca chloride, Ca acetate, and Ca acetate solution containing silver nitrate. | The nanostructured topography of the coating resulted in a reduction in bacterial adhesion and proliferation, even in the absence of Ag. The cost-effective approach provided protection against the most predominant bacterial colonizers of the Ti porous implants, while maintaining their bioactivity. | [71] |
| Method | Details of Tests | Materials | Advantages and Drawbacks | Reference |
|---|---|---|---|---|
| in vitro | Methicillin-resistant Staphylococcus aureus | Sodium titanate nanofiber thin film exposed to ultraviolet (UV) light | The bacteria could be prevented from growing and adhering to a sample when the sample was stored under UV irradiation. | [44] |
| in vitro | Escherichia coli (Gram-negative strain) and Staphylococcus aureus (Gram-positive strain) | Magnesium titanates (Ti-AMg) | For E. coli, the antibacterial efficacy (BR) was approximately 30% for Ti and 95% for Ti-AMg. For S. aureus), the BR was 27% for Ti and 88% for Ti-AMg. | [24] |
| in vitro | Staphylococcus aureus | Compound layer (comprising calcium titanate and hydroxyapatite) deposited by MAO | The porous coating’s structure enabled outstanding mechanical integration as bone cells infiltrated its pores. The addition of silver significantly inhibited the proliferation of S. aureus colonies. | [40] |
| in vitro | Gram-negative (Pseudomonas aeruginosa and Escherichia coli) and Gram-positive (S. aureus and S. epidermidis) strains | Porous calcium titanate coatings with incorporated silver ions | The treated surfaces exhibited no cytotoxicity and formed an apatite layer across the entire porous surface upon immersion in simulated body fluid. The release of Ag leads to a strong antibacterial effect, effectively inhibiting bacterial adhesion and proliferation. | [71] |
| in vitro | Escherichia coli and Staphylococcus aureus | Barium titanate coatings | BaTiO3 effectively inhibited the growth of E. coli and S. aureus. Higher concentrations of BaTiO3 resulted in greater inhibition of bacterial growth. | [18] |
| in vitro | Escherichia coli and Staphylococcus aureus | Ag-doped calcium titanate coatings on the Ti surface obtained by the thermochemical treatment | The silver liberation from porous implants helps to deter bacterial adhesion for extended periods. | [14,15,82] |
| in vitro | Escherichia coli and Staphylococcus aureus | TiO2 coatings on the Ti surface obtained by the thermochemical treatment | Surface roughness at the microscale increases bacterial proliferation and biofilm formation. | [83,84] |
| in vitro | Osteoblasts, Pseudoalteromonas issachenkonii, S. aureus, S. epidermidis, Pseudomonas aeruginosa | Nanostructured TiO2, etched glass, Ti | Nano-roughness tends to hinder bacterial attachment. | [85,86,87,88,89] |
| in vitro | Mouse mesenchymal stem cells (C3H10T1/2) and human osteoblast-like cells (MG63) | Nanostructures formed on the magnesium titanates | Expression of osteogenic factors was notably increased for the Ti-AMg sample compared with bare titanium. | [24] |
| in vitro | Human osteoblast-like cells (SaOS-2) | Ca titanate obtained by immersion in a Ca acetate solution (100 mM) mixed with 10 mL Ga and Ag nitrate solutions | The introduction of gallium on the titanium surfaces supported human osteoblast-like cell (SaOS-2) adhesion, proliferation, and differentiation. | [30] |
| in vitro | Pseudomonas aeruginosa, Escherichia coli, Staphylococcus aureus, and Staphylococcus epidermidis | Ca titanate obtained by immersion in a Ca acetate solution (100 mM) mixed with 10 mL Ga and Ag nitrate solutions | The introduction of gallium on the titanium surfaces enhanced the antibacterial effect against Gram-positive strains. The inclusion of silver almost completely suppressed bacterial adhesion and proliferation for both the Gram-positive and -negative strains. | [30] |
| in vitro | Escherichia coli and Staphylococcus aureus | Three-step process involving mineralization and ion exchange to synthesize lamellar magnesium calcium phosphate thin films | The films possessed highly osteogenic effects triggered by the release of Ca2+ and PO43− (II) and subsequently facilitated bacterial eradication (S. aureus and E. coli) through the release of Mg2+ in challenging infected scenarios. | [36] |
| in vivo | Injection of rats with Staphylococcus aureus | Titanium (AT), AT–calcium phosphate (AT-CaP), and AT–magnesium–calcium phosphate (AT-Mg2-CaP) implanted into femur and knee joints of rats | The hierarchical AT-Mg2-CaP coating system not only exhibited prolonged bacteriostatic properties but also played a crucial role in preventing late infections at the bone–implant interface. | [36] |
Disclaimer/Publisher’s Note: The statements, opinions and data contained in all publications are solely those of the individual author(s) and contributor(s) and not of MDPI and/or the editor(s). MDPI and/or the editor(s) disclaim responsibility for any injury to people or property resulting from any ideas, methods, instructions or products referred to in the content. |
© 2024 by the authors. Licensee MDPI, Basel, Switzerland. This article is an open access article distributed under the terms and conditions of the Creative Commons Attribution (CC BY) license (https://creativecommons.org/licenses/by/4.0/).
Share and Cite
Straumal, B.B.; Kurkin, E.N.; Balihin, I.L.; Klyatskina, E.; Straumal, P.B.; Anisimova, N.Y.; Kiselevskiy, M.V. Antibacterial Properties and Biocompatibility of Multicomponent Titanium Oxides: A Review. Materials 2024, 17, 5847. https://doi.org/10.3390/ma17235847
Straumal BB, Kurkin EN, Balihin IL, Klyatskina E, Straumal PB, Anisimova NY, Kiselevskiy MV. Antibacterial Properties and Biocompatibility of Multicomponent Titanium Oxides: A Review. Materials. 2024; 17(23):5847. https://doi.org/10.3390/ma17235847
Chicago/Turabian StyleStraumal, Boris B., Evgenii N. Kurkin, Igor L. Balihin, Elisaveta Klyatskina, Peter B. Straumal, Natalia Yu. Anisimova, and Mikhail V. Kiselevskiy. 2024. "Antibacterial Properties and Biocompatibility of Multicomponent Titanium Oxides: A Review" Materials 17, no. 23: 5847. https://doi.org/10.3390/ma17235847
APA StyleStraumal, B. B., Kurkin, E. N., Balihin, I. L., Klyatskina, E., Straumal, P. B., Anisimova, N. Y., & Kiselevskiy, M. V. (2024). Antibacterial Properties and Biocompatibility of Multicomponent Titanium Oxides: A Review. Materials, 17(23), 5847. https://doi.org/10.3390/ma17235847

